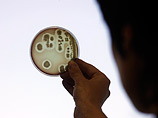

|
 |
 |
 |
| ||||||||||||
 |
Вокруг света
Смертельный штамм, убивший 42 человека в Германии, может находится в питьевой воде
3:54PM Sunday, Jun 26, 2011
Бактерия-возбудитель кишечной инфекции, от которой в Германии скончались 42 человека, может находиться в питьевой воде, предупреждают эксперты. Об этом сегодня сообщает еженедельник Der Spiegel. "Мы не исключаем, что бактерия уже "окопалась" в окружающей нас среде, - отметил в интервью журналу Хельге Карх, директор Института гигиены университетской клиники в Мюнстере. - Она приспосабливается и может вновь попадать к людям". После того, как возбудитель был найден в водоеме недалеко от Франкфурта-на-Майне, специалисты предполагают, что бактерия может находиться в питьевой воде. "Опасность заражения питьевой воды абсолютно недооценивается", - отметил, в свою очередь, Мартин Экснер, директор боннского Института гигиены в университетской клинике и одновременно председатель комиссии Федерального ведомства по охране окружающей среды. По его словам, особенно опасно попадание возбудителя в водопроводную систему в сельской местности, где качество воды проверяется гораздо реже, нежели в областях с высокой плотностью населения. Так, согласно исследованию, проведенному Всемирной организацией здравоохранения (ВОЗ), в земле Баден-Вюртемберг в 5 процентов проб питьевой воды из небольших водопроводных систем и в воде из каждого второго частного колодца содержатся кишечные бактерии.
По материалам NewsRu.com
Другие новости по теме
• Toyota отзовет 111 тысяч гибридов из-за неисправных транзисторов…• Третий пилот команды Sauber одержал дебютную победу в GP2… • Жена лидера иракской "Аль-Каеды" получила 20 лет тюрьмы… • Фредди Лойкс в седьмой раз выиграл домашнее Ралли Ипра… • Испытания "Булавы" возобновятся 28 июня… • В лидеры чемпионата GP3 вышел 17-летний пилот… • Гран-при "Каннских львов" в номинации Film достался Nike… • Единственное фото Билли Кида продали за два миллиона… • Марко Андретти одержал вторую в карьере победу в INDYCAR… • Пара из Израиля получила условный срок за кражу ложек из Освенцима… • Китай выпустил из тюрьмы лауреата премии Сахарова… • Армия Мексики заменила полицию в 22 городах на границе с Техасом… • Роман Гросжан одержал победу в первой гонке GP2 в Валенсии… • Эрик Булье пригласил Марка Уэббера в команду Renault… • Братт выиграл дождевую гонку Формулы-2 в Бельгии… • Феттель стартует с поул-позиции на Гран-при Европы…
|
| News Central Home | News Central Resources | Portal News Resources | Help | Login |